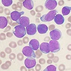

Сергей Эрнестович Аракелов
Онколог, кандидат медицинских наук. Город: Москва. Должность: врач.


Карточка врача
 пн,вт,ср,чт,пт 8:00 до 14:00
пн,вт,ср,чт,пт 8:00 до 14:00 пн,вт,ср,чт,пт 8:00 до 14:00
пн,вт,ср,чт,пт 8:00 до 14:00- Возраст:
- 54 года
- Пол:
- мужской
- Опыт работы:
- 20 лет
- Количество пролеченных больных по основной специальности (за год):
- 348
- Методы лечения:
- консервативные: лекарственные, консервативные
хирургические: лапаротомия, малоинвазивная хирургия, эндоскопический доступ
инновационные методы лечения - Языки:
- английский
- Образование (первое, дополнительное, за границей):
- не указано
- Дополнительные навыки и знания:
- не указаны
- Общества в которых состоит:
- Российское общество онкологов
Специализация на заболеваниях:
-

Это образования половых органов, сопровождающиеся развитием ракового процесса. Могут локализоваться в яичнике (папиллярная цистаденома, некоторые виды тератом), в шейке матки, в теле матки.
Лейкемия (лейкоз, рак крови) - злокачественное заболевание клеток крови, связанное с неконтролируемой продукцией костным мозгом аномальных лейкоцитов, неспособных выполнять защитные функции в организме, вытесняющих нормальные клетки крови, накапливающиеся в лимфоузлах или других органах, вызывая их увеличение.

Опухолевые заболевания крови, обусловленные неконтролируемым избыточным образованием в лимфоцитах белков, способствующих резкому повышению вязкости крови, нарушению микроциркуляции в органах, поражению почек, повышенной кровоточивости, предрасположенности к инфекциям.

Опухоль из специфических лимфоидных клеток Березовского-Штернберга-Рида, замещающих нормальную ткань в лимфатических узлах, селезенке, костном мозге и других органах, вызывая сдавление, нарушение функции и острую интоксикацию.

Опухоли из клеток крови, которые полностью замещают нормальную ткань лимфатических узлов, селезенки, вызывая бурный рост и сдавление окружающих тканей.

Злокачественная опухоль из кроветворных клеток крови, характеризуется неконтролируемым ростом измененных бластных клеток с поражением жизненно важных органов.

Злокачественная опухоль из перерожденных лимфоцитов, которые поражают за счет прорастания в слизистые оболочки внутренних органов, селезенку, головной мозг.

Приобретенная болезнь, обусловленная разовым кратковременным действием энергии ионизирующего излучения в дозе 1 Грэй, с выраженным необратимым поражением клеток костного мозга, органов желудочно-кишечного тракта и кожи за счет ионизации молекул внутриклеточной воды, приводящей к разрушению ДНК клеток.

Детская врожденная злокачественная опухоль сетчатки глаза. Причиной заболевания является мутация гена –Rbl в 13 хромосоме.

Детская врожденная злокачественная опухоль сетчатки глаза. Причиной заболевания является мутация гена –Rbl в 13 хромосоме.

Генетическое заболевание, при котором образуются доброкачественные опухоли во многих внутренних органах. Причиной заболевания является мутация генов TSC1 и TSC2 .

Болезнь Бурневилля-Прингла (син. Туберозный склероз) - разрастание ткани мозга в виде узелков или бугорков различной величины, плотных на ощупь, локализующихся в коре головного мозга, белом веществе, подкорковых структурах, мозжечке, стволе и желудочках мозга, спинном мозге.

Генетическое заболевание, при котором образуются доброкачественные опухоли во многих внутренних органах. Причиной заболевания является мутация генов TSC1 и TSC2 .

Рак шейки матки - злокачественная опухоль шейки матки, возникающая из слизистой оболочки шейки и шеечного канала.

Саркома - группа злокачественных опухолей, происходящих из мезодермы (незрелой соединительной ткани), для которых характерно безудержное разрастание их плохо дифференцированных клеток, прорастание в соседние ткани и органы и перенос в отдалённые органы (метастазы).

Базалиома - опухоль поверхностного слоя кожи, связанная с нарушением роста и размножения стволовых клеток эпидермиса.

Меланома - злокачественная опухоль кожи и (реже) слизистых оболочек, растущая из меланоцитов - клеток содержащих меланин.

Злокачественная опухоль, развивающаяся из соединительной ткани кожи, склона к метастазированию и рецидивированию. К причинам саркомы кожи относят заражение вирусом Эпшпейн-Бара, иммунодефицитное состояние, ВИЧ-инфекция, наследственная предрасположенность, работа на вредных производствах и объектах повышенной радиационной опасности.

Опухоль, локализованная в яичниках у женщин, в яичках у мужчин, в крестцово-копчиковой области у детей. Состоит из зародышевых тканей.

Доброкачественная, часто врожденная опухоль из клеток лимфатических сосудов. Представляет собой тонкостенную кисту (полость).
-

Быстро прорастают в соседние органы и ткани, но метастазируют относительно поздно. Провоцирующими факторами являются: полипозные синуситы, травмы, запыленность воздуха (особенно в промышленных помещениях, курение, вирус папилломы человека).

В возникновении рака немалое значение имеют такие факторы как курение, контакт с продуктами переработки и сгорания нефти, красками, асбестовой пылью и пр.

Это образования доброкачественной или злокачественной природы. Основной причиной возникновения этих опухолей являются нарушения в эмбриональном развитии у человека.

Рак молочной железы - злокачественное новообразование в железистой ткани молочной железы. К раку молочных желез может приводить наследственная предрасположенность (бабушка или мать болели раком молочной железы), воспалительные заболевания яичников и матки, позднее начало менструаций, аборты в анамнезе, отсутствие родов, позднее рождение первого ребенка, отказ от грудного вскармливания, нерегулярная половая жизнь, гормональные нарушения, гипертония, атеросклероз, сахарный диабет, курение, особенности питания с высоким потреблением животных жиров.

Рак легкого - злокачественная эпителиальная опухоль легкого. Существует центральный рак легкого, развивающийся из крупного бронха и периферический рак - из ткани более мелкого бронха.

Злокачественная опухоль слизистой оболочки пищевода. Возникновению рака пищевода способствуют повреждения слизистой оболочки пищевода вследствие химических ожогов, термических ожогов, регулярного употребления горячей пищи в горизонтальном положении, обострения хронических болезней желудка за счет заброса желудочного сока и кислот в пищевод, курение и злоупотребление алкоголем.

Рак желудка - злокачественная опухоль из клеток слизистой оболочки желудка. Опухоль может возникнуть в любом отделе желудка.

Злокачественная опухоль слизистой оболочки прямой кишки. К основным причинам, приводящим к раку прямой кишки, приводят хронические воспалительные заболевания сигмовидной и прямой кишки, хронические запоры, травмы прямой кишки с образование трещин, единичные и множественные полипы.

Злокачественная опухоль слизистой оболочки толстой кишки. Возникновению рака толстой кишки способствуют хронические воспалительные заболевания толстой кишки и распространенные множественные полипы толстой кишки, употребление в пищу продуктов горячего и холодного копчения, напитков живого брожения, хронические запоры.

Рак мочевого пузыря-злокачественная опухоль слизистой оболочки или всей толщи стенки мочевого пузыря. К причинам ,способствующим возникновению р.

Злокачественная опухоль мозга. Выделяют первичный рак головного мозга, который вырастает из опухолевых клеток головного мозга, и вторичный рак головного мозга, который образуется за счет роста клеток, проникающих в головной мозг из других органов, пораженных раком.

Злокачественная опухоль, вырастающая из предстательной железы. Возникновению рака простаты способствует гормональный дисбаланс у мужчин преимущественно пожилого возраста, наследственная предрасположенность, особенности питания с высоким употреблением животных жиров и холестерина.

Рак печени - злокачественная опухоль, локализующаяся в печени. Выделяют первичный рак, который вырастает из клеток и структур печени и вторичный, который образуется за счет роста клеток, проникающих в печень из других органов, пораженных раком (метастазирование).

Злокачественная опухоль слизистой оболочки желчного пузыря. Раку желчного пузыря способствуют хронические бактериальные и паразитарные заболевания желчного пузыря и желчевыводящих путей, язвенная болезнь двенадцатиперстной кишки, нарушение обмена веществ, сахарный диабет.

Злокачественная опухоль поджелудочной железы. К основным причинам рака поджелудочной железы относятся курение, длительное злоупотребление алкоголем, особенности питания с употреблением пищи богатой животными жирами, наследственная предрасположенность, сахарный диабет, хронические болезни печени с развитием цирроза печени, кисты поджелудочной железы вследствие острых панкреатитов или травм поджелудочной железы.

Злокачественная опухоль почки, растущая из структуры почечной ткани, эпителия чашечек и лоханки. Возникновению рака почки способствуют курение, связанные с наследственностью заболевания, работа на вредных производствах (контакт с анилиновыми красителями).

Злокачественная опухоль яичка, растущая из семенных канатиков или железистой ткани яичка. Возникновению рака яичка способствуют травмы наружных половых органов, наследственная предрасположенность, нарушение развития яичка, вирусные заболевания яичка.

Рак матки - злокачественная опухоль, растущая из эндометрия. К основным причинам развития рака матки относятся хронические воспалительные заболевания матки и ее придатков, заражение вирусом папиломы человека, гормональный дисбаланс, неконтролируемый прием гормональных контрацептивов, наследственная предрасположенность, малое количество или отсутствие родов, ожирение, сахарный диабет, курение и др.

Злокачественная опухоль слизистой оболочки толстой кишки. Возникновению рака толстой кишки способствуют наследственность, злоупотребление жирной пищей с высоким содержанием животных жиров, холестерина, продуктов горячего и холодного копчения.

Достаточно редко встречающееся заболевание. Опухоль может развиться первично, а также путём метастазирования из других органов.
Поиск врачей большая работа, которую мы вам максимально постарались упростить. Будьте здоровы!









 Оставить отзыв:
Оставить отзыв:














